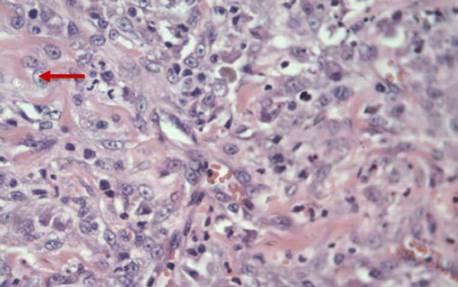

RESUMEN: Los mastocitomas son tumores originarios de los mastocitos que usualmente afectan a los perros y los gatos. Pueden llegar a tener un comportamiento benigno, sin embargo, esto dependerá del grado de la neoplasia y su estadiaje. En felinos, clínicamente se han descrito dos patrones: visceral y cutáneo, de los cuales el cutáneo es el más frecuente, llegando a causar metástasis a órganos adyacentes e incluso afectar el bazo y/o intestino en estadios más diferenciados. Se presenta un caso de mastocitoma felino correspondiente a un ejemplar mestizo con cuadro clínico de inicio de más de dos meses de evolución, consistente en la aparición de una placa alopécica ulcerada y elevada en región interescapular, acompañada de prurito que presentó resolución espontánea. Mediante el curso clínico se imnunizó contra el virus de la rabia, posteriormente, se observó la aparición de una lesión nodular subcutánea de características inusuales de 2cm de diámetro. Acorde con el tiempo de evolución y el antecedente vacunal se decidió la realización de biopsia y resección quirúrgica. El reporte de la biopsia confirmó diagnóstico de mastocitoma grado histológico 3 de Patnaik, teniendo en cuenta las características histológicas, estructurales y su comportamiento clínico. Se realizó seguimiento del caso pasados ocho meses, donde se evidenció mejoría del cuadro clínico, sin aparición de nueva masa sugestiva de neoplasia, sin hallazgos de metástasis a otras estructuras, con cicatrización exitosa de herida quirúrgica y evolución satisfactoria.
Palabras clave: tumores cutáneostumores cutáneos,tumores del cuello y caratumores del cuello y cara,mastocitomamastocitoma,felinofelino.
ABSTRACT: Mast cells are tumors originating from mast cells which usually affect cats and dogs. They may have benign behavior, however, this will depend on the degree of the neo-plasm and its staging. In cats, two patterns have been described clinically: visceral and cutaneous, of which the cutaneous form is the most frequent, reaching metastasis to adjacent organs and even affecting the spleen and / or intestine in more differentiated stages. A case of a mastocytoma is presented, a feline corresponding to a mongrel specimen with a clinical picture of onset of more than two months of evolution, consisting of the appearance of an allopecal plaque, ulcerated and elevated in the interscapular region, accompanied by pruritus that presented spontaneous resolution. Through the clinical course, he was immunized against the rabies virus, later the appearance of a nodular lesion of unusual subcutaneous characteristics, 2 cm in diameter, was observed. According to the evolution time and the vaccination history, it was decided to perform a biopsy and surgical resection. The biopsy report confirmed the diagnosis of Patnaik's histological grade 3 mastocytoma, taking into account the histological and structural characteristics and its clinical behavior. The case was followed up after eight months, where an improvement in the clinical picture was evident, without the appearance of a new mass suggestive of neoplasia, without metastatic findings to other structures, with successful healing of the surgical wound and satisfactory evolution.
Keywords: skin tumors, neck and face tumors, mastocytoma, feline.
Reporte de caso
Feline mastocytoma. Case report
Mastocitoma felino. Reporte de caso
Facultad de Medicina Veterinaria y de Zootecnia Universidad Nacional de Colombia
Recepción: 03 Octubre 2020
Aprobación: 27 Agosto 2020
Los mastocitomas son tumores originarios de los mastocitos o células mastocíticas que se definen como una proliferación neoplásica de dichas células. Los mastocitomas cutáneos se originan de los mastocitos de la dermis y constituyen un tipo de tumor frecuente en caninos y felinos. Los mastocitos se originan en la médula ósea a partir de células precursoras, posteriormente, migran a diversos tejidos, principalmente aquellos que tienen contacto con antígenos externos tales como la piel o los sistemas respiratorio y digestivo (Abbas et al. 2000). Los mastocitos contienen en su citoplasma moléculas vasoactivas como la heparina, la histamina, citoquinas y leucotrienos, entre otros; estos mediadores actúan en diferentes situaciones, como la permeabilidad vascular, la vasodilatación, el prurito, en mecanismos anticoagulantes y en la activación de eosinófilos y neutrófilos. Los mastocitos, por lo tanto, están relacionados con las reacciones alérgicas; sin embargo, se ha encontrado un papel muy importante del mastocito frente a la respuesta inmunitaria, principalmente en la migración celular de neutrófilos en respuesta a una infección bacteriana (Abbas et al. 2000).
Estudios recientes sugieren el papel de un gen supresor de tumor o mutaciones del oncogen en el desarrollo del tumor (Miller et al. 2012). El factor de células madre (SCF) es un ligando kit, un receptor de tirosina quinasa que se expresa en varias células, incluidos los mastocitos (Lennartsson y Rõnnstrand 2012). El SCF es importante para la proliferación, desarrollo, migración y supervivencia de mastocitos (Okayama y Kawakami 2006); la proteína del kit está codificada por el c-kit protooncogen. Aunque los mecanismos detallados no se entienden completamente, las mutaciones c-kit resultan en la autoactivación de la proteína kit sin interacción con ligandos (Lennartsson y Rõnnstrand 2012). Las mutaciones en c-kit están involucrados en la tumorigénesis de los tumores de mastocitos (Lennartsson y Rõnnstrand 2012). Por su parte, Amagai et al. (2013) sugirieron que las acciones auto-crinas / paracrinas de SCF pueden ser un mecanismo de tumorigénesis novedoso; en ese estudio se demostró que SCF se expresaba altamente en la línea celular de mastocitos caninos y se sugirió que las expresiones SCF contribuían a la fosforilación de kit, dando como resultado la proliferación de las células. Además, la expresión de SCF se ha detectado en casos clínicos de tumorigénesis de mastocitos caninos y se ha asociado con la proliferación tumoral (Amagai et al. 2014). Por su parte, en los felinos los tumores de mastocitos son comunes y ocurren como neoplasias cutáneas o como mastocitosis de origen visceral (Ginn et al. 2007; Henry y Herrera 2013). Los informes de c-kit de las mutaciones en felinos son limitados, pero el comportamiento de los tumores de mastocitos felinos sin c-kit reportan mutaciones (Dank et al, 2002; Isotani et al. 2010). Un estudio realizado por Sabattini et al. (2017) no mostró correlación entre las mutaciones c-kit, la diferenciación tumoral y la actividad mitótica o la supervivencia en felinos. Se considera que los tumores de mastocitos en felinos tienen mecanismos de tumorigénesis similar a la de humanos y perros. Sin embargo, hasta la fecha no ha sido reportada alguna mutación de c-kit asociada con tumores de mastocitos en felinos. No obstante, a pesar de la evidencia científica disponible su etiología sigue siendo desconocida (Govier 2003; Miller et al. 2012).
Originado de los mastocitos del tejido conectivo, el mastocitoma es descrito como la segunda neoplasia cutánea más frecuente en felinos, representando el 21,1% de los casos (Miller et al. 1991) y su incidencia se cifra alrededor del 15% de todos los tumores cutáneos en gatos (Ríos et al. 2008). Se ha descrito en la literatura una media de edad de los animales afectados de 7,2 años o un rango de entre 8 y 9 años, mientras que en otras fuentes se clasifica dependiendo del tipo de forma cutánea, encontrándose una edad de presentación alrededor de 9 años en la forma cutánea mastocítica, y entre los 2,5 y los 10 años en la forma cutánea histiocítica (Ríos et al. 2008). No se ha encontrado predisposición en cuanto al sexo, ni tampoco relación entre el virus de la leucemia, inmunodeficiencia y la peritonitis infecciosa felina con el mastocitoma felino (Scott et al. 2001; Couto 2003; Vail 2003). Las razas más afectadas son felinos de pelo corto doméstico. Sin embargo, los gatos siameses parecen estar predispuestos a las dos formas de presentación cutánea (Gross et al. 2005; Miller et al. 2012).
Presentación visceral: esta forma predomina más en gatos que en perros, llegando a ser responsable del 50% de los casos. Afecta el sistema hemolinfático y digestivo y se caracteriza generalmente por compromiso esplénico (mastocitoma linforeticular) caracterizado por esplenomegalia; en algunas ocasiones se encuentra hepatomegalia como manifestación de una mastocitosis, como por metástasis de la mastocitosis esplénica, la cual resulta ser la causa más frecuente (Ríos et al. 2008). Estos animales tienen mayores riesgos de diseminación y metástasis. Se pueden presentar casos de mastocitosis periférica, de efusión pleural y abdominal, donde la citología del líquido revela un gran número de mastocitos y de eosinófilos.
Los síntomas clínicos asociados a esta presentación visceral incluyen anorexia, vómitos y anemia por pérdida crónica de sangre. La esplenectomía es el tratamiento de elección, con un promedio de supervivencia estimado de 14 meses. En algunos pacientes se presenta un mastocitoma intestinal, el cual se observa como una masa intestinal única, aunque los síntomas clínicos son parecidos a la forma visceral, se pueden encontrar signos sugestivos de obstrucción intestinal y los síntomas correspondientes a esta; para este caso, la cirugía es el tratamiento de elección, sin embargo, el tiempo de supervivencia es bajo (menor de 3 meses) (Ríos et al. 2008).
Presentación cutánea: su manifestación clínica es variable, se presenta tanto en caninos y felinos, pero con mayor frecuencia en felinos (Miller et al. 2012), se han descrito dos formas: forma cutánea mastocítica, similar al mastocitoma canino y la forma cutánea histiocítica, menos frecuente y morfológicamente más semejantes a las histiocitosis (Vail 2003).
Forma cutánea histiocítica: esta forma suele presentarse como nódulos subcutáneos en la zona de la cabeza y el cuello que pueden desaparecer de forma espontánea (Ríos et al. 2008).
Forma cutánea mastocítica: la cual se clasifica a su vez en dos categorías, la compacta y la difusa. La forma cutánea mastocítica compacta es la más frecuente, ocupa entre el (80-90%) y se caracteriza por tener un comportamiento más benigno (Ríos et al. 2008); en contraposición, la forma cutánea mastocítica difusa es histológicamente más anaplásica y maligna (Vail 2003).
La presentación clínica clásica del mas-tocitoma cutáneo en felinos es un nódulo dérmico solitario y bien definido, sin pelo (alopécico) y de un tamaño entre 0,5-3 cm de diámetro, se presenta ulceración superficial en aproximadamente un cuarto de los casos, suele ser no pigmentado, aunque en ocasiones es ligeramente rosado (Ríos et al. 2008). Entre las localizaciones más frecuentes se encuentran la cabeza, el cuello y las patas (Lepri et al. 2003; Miller et al. 2012), pero también puede ocurrir en el tronco (Miller et al. 1991; Sabattini et al. 2017). Los tumores menos diferenciados pueden aparecer de forma múltiple, sobre todo en la zona de la cabeza (Ríos et al. 2008).
El diagnóstico puede ser obtenido a través de un examen citológico o histológico, pudiendo realizar aspirado con aguja fina u otro método de biopsia. La clasificación histológica es un indicador en cuanto al comportamiento del mastocitoma, que puede ser clasificado en histiocítico o mastocítico (Govier 2003); otra clasificación utilizada incluye el bien diferenciado, diferenciado, atípico poco granulado y el pleomórfico, en el cual el mastocítico (forma cutánea mastocítica) es dividido en: bien diferenciado (forma compacta) y pleomórfica (forma difusa) (Blackwood et al. 2012). Esta última se utiliza para determinar el grado de la neoplasia.
La clasificación de la neoplasia bien diferenciada se asocia a un comportamiento más benigno (Govier 2003). Sin embargo, otros autores refieren que en la actualidad no existe un sistema de clasificación para el mastocitoma felino, y la identificación de tumores con comportamiento maligno sigue siendo un desafío en la práctica clínica. La actividad mitótica se considera en la mayoría de los estudios como el único factor pronóstico en su evolución (Henry y Herrera 2013), teniendo en cuenta que las pocas figuras de mitosis observadas denotan un comportamiento menos agresivo, mientras que la tasa elevada de mitosis se describe como característica indicativa de un comportamiento agresivo.
El tratamiento de elección es la resección quirúrgica (Govier 2003; Wright y Chretin 2006) y como la mayoría de estos tumores tienen un comportamiento benigno, la cirugía con escisión amplia no es crucial (Govier 2003); sin embargo, la extirpación quirúrgica está indicada en gatos que no presenten más de cinco tumores cutáneos o en aquellos pacientes que presenten solo afección visceral (Ríos et al. 2008). En este último caso, la extirpación quirúrgica debe ir acompañada de quimioterapia. La evaluación de terapia adyuvante como radiación o quimioterapia no son sistemáticamente realizadas (Ríos et al. 2008); otros autores han mencionado que la quimioterapia no parece aumentar el tiempo de supervivencia a pesar de la literatura escasa (Miller et al. 2012). El tratamiento con prednisona a dosis de 4-8 mg/Kg V.O. cada 24-48 horas ha demostrado ser efectivo en gatos con afección sistémica o en casos donde exista evidencia de metástasis. Adicionalmente, es importante reconocer el uso de algún agente quimioterapéutico adicional como el clorambucilo (20 mg/ m2 V.O. cada 2 semanas) con el objetivo de servir de manejo complementario eficaz (Ríos et al. 2008).
Un felino mestizo, macho, castrado, atigrado, de pelo corto, de 1,5 años de edad y de 4,40 kg de peso presentó un cuadro clínico de 2 meses de evolución consistente en la aparición de una placa alopécica, ulcerada y elevada en la región interescapular a nivel del cuello (Figura 1), la cual se acompañó de prurito y al cabo de un tiempo presentó resolución espontánea. Posteriormente, el paciente fue inmunizado contra el virus de la rabia en la misma zona de lesión descrita que ya se encontraba en fase de resolución. Siguiendo la evolución clínica, 7 días después de la inmunización apareció en la misma localización un nódulo bien definido, con región alopécica y ulcerado, eritematoso, duro, de aspecto subcutáneo y de 2cm de diámetro (Figura 2A, 2B y 2C), el cual fue valorado por un médico veterinario en un centro hospitalario quien corroboró en el examen físico los hallazgos clínicos mencionados.

FIGURA 1
Lesión inicial. Placa alopécica, ulcerada, elevada de bordes irregulares de aproximadamente de 3x2 cm de diámetro en la región interescapular a nivel del cuello. Nótese la presencia en el centro de un lecho de granulación y en la periferia tejido epitelial.

FIGURA 2
Lesión posterior a la aplicación de vacuna. Nódulo alopécico, ulcerado y con costra serohemática en la región interescapular a nivel del cuello (A y B). La misma lesión post rasurada (C).
Se sospechó un fibrosarcoma postvacunal, consecuente con el tiempo de evolución y el antecedente vacunal, por lo que se decidió realizar biopsia y resección quirúrgica. Posteriormente, se tomaron paraclínicos parasitológicos, micóticos, al igual que raspado cutáneo para descartar diagnósticos diferenciales, con reporte de resultado negativo para ácaros y hongos. Adicionalmente, se realizaron exámenes pre-quirúrgicos (hemograma, uroanálisis, creatinina) con resultados en rangos de normalidad. Seguidamente se procedió a la cirugía electiva por la sospecha de fibrosarcoma postvacunal, se llevó a cabo resección quirúrgica tomando bordes de 3cm para lograr márgenes quirúrgicos grandes y limpios en espera de que la resección fuese curativa, dichos márgenes midieron en conjunto 5x3x1 cm de espesor y se identificaron unas zonas gruesas de color gris y zonas de color café oscuro en la dermis.
En el examen histológico se encontró en la dermis profunda un nódulo de bordes mal definidos y de aspecto infiltrativo compuesto por células grandes y de citoplasmas amplios, adicionalmente, se evidenciaron gránulos intracitoplasmáticos de color violáceo infiltrando difusamente fibras colágenas y borrando parcialmente la arquitectura, acompañados de necrosis y formación de microabscesos, con hallazgos de proliferación celular compatible con mastocitoma de grado histológico 3 (Figura 3A, 3B, 3C, 3D), lo que confirmó el diagnóstico teniendo en cuenta las características histológicas y estructurales.

FIGURA 3A
Tinción con H&E (hematoxilina y eosina) que muestra sección de piel. La dermis está comprometida por lesión de bordes infiltrativos que compromete la dermis superficial y profunda (flechas). Se observa compromiso de anexos cutáneos, también se observa perdida de la solución de continuidad dermoepidermica (*). Aumento 4X.

FIGURA 3B
Muestra de biopsia de una lesión por mastocitoma felino teñida con H&E, donde se puede apreciar células grandes de citoplasmas amplios, núcleos redondos con gránulos intracitoplasmaticos de color violáceo (flecha). Dichas células infiltran difusamente fibras colágenas separándolas y demostrando el carácter infiltrativo de la neoplasia. (La celularidad es muy homogénea). Aumento 40X.

FIGURA 3C
Tinción H&E de una lesión por mastocitoma felino donde se observa infiltrado difuso que compromete tejido graso y el tejido conectivo. Nótese la disgregación del tejido y la presencia de células inflamatorias. Aumento 20X.

FIGURA 3D
Examen histopatológico teñido con H&E, donde se observa el borde de la lesión tumoral y la dermis. Nótese la característica infiltrativa de la lesión. Aumento 10X.
El tratamiento de elección fue la resección de la neoplasia, con márgenes quirúrgicos que miden en conjunto 5x3x1cm de espesor. La premedicación anestésica consistió en la administración intramuscular de una combinación de dexmedetomidina (2 ug/ kg) y metadona (0,3 mg/kg). Se cateterizó una vena cefálica y 30 minutos después de la premedicación se indujo la anestesia con propofol a dosis-efecto (2 mg/kg). La tráquea fue intubada con un tubo orotraqueal del n.° 12 con sistema de neumotaponamiento. Se conectó al paciente a un circuito circular y el mantenimiento anestésico se inició con isofluorano vehiculado en 1 lpm de oxígeno al 100%; adicionalmente, durante el mantenimiento anestésico se administró una Solución Lactato de Ringer. (5 ml/kg/h).
Tras preparar asépticamente al felino se realizó una técnica de analgesia/anestesia regional y se cateterizó la arteria pedal dorsal de la extremidad posterior derecha para la monitorización de la presión arterial y la toma de muestras para gasimetría arterial. La anestesia transcurrió sin contratiempos y el procedimiento quirúrgico finalizó sin complicaciones; tras recuperar al animal se administró meloxicam (0,2 mg/kg). Finalizada la intervención se evidenció una herida quirúrgica limpia de 7cm de longitud en región interescapular y cuello, la cual se cerró por planos profundos hasta piel con puntos de sutura simple con prolene 3-0 (Figura. 4A). Finalmente, el paciente se dio de alta y se prescribió un régimen de antibiótico y una solución tópica antiséptica Clorhexin® Spray (clorhexidina digluconato) para la realización de limpieza de la zona quirúrgica dos veces al día y una crema pro cicatrizante Pezosan-N® (neomicina sulfato, alantoína, lidocaína y óxido de zinc) para aplicar posterior a la limpieza. Adicionalmente, debido a la localización y magnitud de la herida, se recomendó el uso de traje quirúrgico (Figura 4B) en lugar del collar isabelino, con el propósito de evitar lesiones de la herida y estrés del felino.

FIGURA 4
A. Zona postquirurgica en región interescapular y cuello, nótese la gran dimensión de esta herida quirúrgica limpia con puntos de sutura simple con prolene 3-0. B. Felino en fase de recuperación con uso permanente del traje postquirurgico, se observa acceso venoso en la extremidad anterior derecha. Postquirúrgico de 3 días.
Un mes después del procedimiento quirúrgico se retiraron los puntos de sutura y se encontró una herida limpia y unida en proceso de cicatrización (Figura 5A). Durante el primer mes postquirúrgico el felino presentó: anorexia, inapetencia y disminución en su defecación en varias ocasiones; sin embargo, los síntomas desaparecieron al final del primer mes. El traje quirúrgico se mantuvo durante un mes posterior a la cirugía, para evitar lesiones inducidas por el gato por medio del rascado. Dos meses después, el animal se encontró en óptimas condiciones, con la herida prácticamente cicatrizada (Figura 5B), apetente, consciente, alerta y activo, con deposiciones y diuresis normales. Al terminarse la crema pro cicatrizante (Pezosan-N®) se continuó con Procicar NF® (óxido de zinc, calamina, D-Pantenol y ácido hialurónico) hasta lograr una óptima cicatrización. Actualmente, la herida se encuentra completamente cicatrizada en fase de maduración "remodelación" (Figura 5C), pelaje sano con total repoblamiento capilar y sin evidencia de reaparición del tumor o metástasis, no obstante, se continúa bajo vigilancia y control.

FIGURA 5
Evolución de herida postquirúrgica. A. Herida roja con tejido de granulación (flecha) en proceso de cicatrización (1 mes post intervención). Nótese la presencia de tejido epitelial en la periferia y una marcada regeneración de la piel en la zona posterior de la cicatriz. B. Herida en fase de epitelización con poco tejido de granulación, nótese el incremento de este tejido epitelial (flecha) con respecto a la imagen anterior, (1.5 meses post intervención). C. Postquirúrgico de 8 meses, se observa total repoblamiento capilar, (pelaje sano, herida totalmente cicatrizada en fase de maduración "remodelación").
En consideración a los signos clínicos presentados en la anamnesis y en el reporte oficial de la histopatología, el animal se diagnosticó con mastocitoma cutáneo grado histológico 3. La localización del nódulo en la región interescapular, a nivel del cuello del animal, coincide por lo descrito por otros autores como uno de los lugares más afectados (Lepri et al. 2003; Miller et al. 2012) y también por ser un nódulo solitario, como el observado en un estudio con 74,07% de los felinos acometidos (Rodríguez-Cariño et al. 2009). A diferencia de la edad referida en la literatura que abarca el rango de 8-9 años, el felino atendido tenía solo un año y medio, algo inusual en este grupo etario. Por su parte, la resección quirúrgica y el informe de la biopsia fueron rápidas y eficaces para obtener el diagnóstico oportuno, lo cual facilitó una mayor prontitud en la decisión de la conducta terapéutica.
El reporte histopatológico es una herramienta eficiente para confirmar el diagnóstico y la clasificación histológica de la neoplasia y ha sido reseñado por otros autores como un indicador de comportamiento y pronóstico de la evolución en la mayoría de los casos (Lepri et al 2003; Miller et al. 2012). Entre los factores más importantes para determinar el grado de la neoplasia están el índice mitótico, la atipicidad de la célula, el citoplasma y núcleo, así como la manera en que se difunde en el tejido, entre otras características microscópicas (Patnaik et al. 1984; Kiupel et al. 2011). En cuanto al pronóstico, se incluye el estadiaje diseminación a linfonodulos, otros órganos, los signos paraneoplásicos y la clasificación de grado histológico, este último fue el que se especificó en el informe de patología y sirvió de apoyo para el diagnóstico de mastocitoma. A pesar de la poca evidencia de casos, la citología y la biopsia siguen siendo los métodos diagnósticos de elección; al respecto, es importante destacar que en este reporte se realizó la biopsia para determinar la histopatología del tejido por la sospecha de fibrosarcoma postvacunal (asociado a la vacuna del virus de la rabia).
Respecto al tratamiento, se optó por la resección quirúrgica del nódulo cutáneo como elección al curso benigno (Miller et al. 2012). La terapia adyuvante con radioterapia o quimioterapia no tuvo indicación, pues el papel de esta modalidad en el tratamiento del mastocitoma felino todavía no ha sido aclarado (Blackwood et al. 2012). Así como en perros, el uso de antihistamínicos H1 y H2 (anti H1 y anti H2) puede ser útil contra los efectos de la degranulación de los mastocitos (Thamm y Vail 2007), siendo los más comunes los signos y síntomas gastrointestinales por la histamina liberada por los mastocitos que estimula receptores H2, que conduce al aumento en la secreción de ácido hidroclorhídrico y gástrico (Fox et al 1990). No obstante, en este reporte no se prescribió esta medicación por la presentación cutánea y no visceral del felino. Sin embargo, se podría administrar como profilaxis ante sospecha de un posible compromiso visceral, o por la presencia de dichos signos y síntomas gastrointestinales.
A pesar del amplio rango de comportamiento biológico, desde benigno a potencialmente maligno, en la actualidad suele ser impredecible emitir un pronóstico del mastocitoma felino; los diferentes estudios realizados en mastocitoma caninos abarcan muchos factores tales como: localización, raza, presencia o no de metástasis, velocidad de crecimiento, índice mitótico, atipicidad de la célula, marcadores de proliferación, signos paraneoplásicos, clasificación de grado histológico, entre otros. Estos factores suelen ser de mucha utilidad y evidencian una idea del compromiso general del animal, aun cuando se desconocen sus factores desencadenantes. La presentación clínica del mastocitoma se considera variable por lo que debe ser sometido a diagnósticos diferenciales. Es importante el control de la evolución del paciente posterior al procedimiento dado el alto riesgo de complicaciones ya que estos tumores pueden llegar a hacer metástasis en bazo y producir compromiso de la motilidad intestinal. Se realizó seguimiento al felino del caso posterior a los ocho meses, donde se evidenció mejoría del cuadro clínico, sin aparición de nueva masa sugestiva de neoplasia, sin presencia de recidivas a lo largo de 1 año de evolución, sin hallazgos de metástasis a otras estructuras, con cicatrización exitosa de herida quirúrgica y evolución satisfactoria.
Por lo general los mastocitomas se consideran tumores con un comportamiento benigno. Sin embargo, se ha encontrado que la actividad mitótica es considerada un indicativo de factor pronóstico tanto de benignidad como de malignidad; así, una baja tasa de mitosis se considera un comportamiento menos agresivo y por el contrario, una tasa elevada se considera un comportamiento agresivo. También es útil la clasificación del grado histológico (bien diferenciado, diferenciado, atípico poco granulado y el pleomórfico), ya que puede distinguir la forma cutánea compacta (bien diferenciado) de la forma difusa (pleomórfica); se destaca por ello como una herramienta adecuada para el diagnóstico, entendiéndose que la clasificación de la neoplasia en bien diferenciada se asocia a un comportamiento más benigno. Adicionalmente, se deben tener en cuenta los factores más importantes para determinar el grado de la neoplasia como el índice mitótico, la atipicidad de la célula, el citoplasma y núcleo, así como la forma en que se difunde en el tejido, entre otras características microscópicas (Patnaik et al. 1984; Kiupel et al. 2011). En cuanto al pronóstico, se incluye el estadiaje diseminación a linfonodulos, a otros órganos, los signos paraneoplásicos, entre otros.
El estudio citológico y la histopatología son herramientas importantes para el diagnóstico de la neoplasia en felinos. El procedimiento quirúrgico es la terapia de elección y hasta el momento no se encuentra evidencia de la necesidad de realización de un protocolo quimioterapéutico en el caso del mastocitoma cutáneo; no obstante, en aquellos pacientes que solo presentan afección esplénica o intestinal la extirpación quirúrgica debe ir acompañada de quimioterapia. De otra parte, en vista de la localización del tumor en el cuello se recomienda la utilización de un traje quirúrgico de preferencia al collar isabelino, para evitar así lesiones o laceraciones que pueda provocar el dispositivo, además de autolesiones provocadas por el felino, como el caso del rascado, además por la notoria disminución de estrés del animal. La administración de cremas procicatrizantes (Pezosan-N® o Procicar NF®) puede ser una buena herramienta para ayudar a mejorar la cicatrización, por su función de protección cutánea, disminuyendo el prurito o comezón, asimismo, intervienen en la prevención de infecciones y aportan condiciones óptimas para una adecuada epitelización del tejido lesionado, lo que conlleva en una mejor cicatrización en menor tiempo. Finalmente, el seguimiento al animal, como en este caso ocho meses después de la intervención, es fundamental para vigilar posibles hallazgos de metástasis a otras estructuras y determinar que no se presenten recidivas a lo largo del tiempo.
* Autor para correspondencia: cesarmorenobabilonia@gmail.com

FIGURA 1
Lesión inicial. Placa alopécica, ulcerada, elevada de bordes irregulares de aproximadamente de 3x2 cm de diámetro en la región interescapular a nivel del cuello. Nótese la presencia en el centro de un lecho de granulación y en la periferia tejido epitelial.

FIGURA 2
Lesión posterior a la aplicación de vacuna. Nódulo alopécico, ulcerado y con costra serohemática en la región interescapular a nivel del cuello (A y B). La misma lesión post rasurada (C).

FIGURA 3A
Tinción con H&E (hematoxilina y eosina) que muestra sección de piel. La dermis está comprometida por lesión de bordes infiltrativos que compromete la dermis superficial y profunda (flechas). Se observa compromiso de anexos cutáneos, también se observa perdida de la solución de continuidad dermoepidermica (*). Aumento 4X.
FIGURA 3B
Muestra de biopsia de una lesión por mastocitoma felino teñida con H&E, donde se puede apreciar células grandes de citoplasmas amplios, núcleos redondos con gránulos intracitoplasmaticos de color violáceo (flecha). Dichas células infiltran difusamente fibras colágenas separándolas y demostrando el carácter infiltrativo de la neoplasia. (La celularidad es muy homogénea). Aumento 40X.

FIGURA 3C
Tinción H&E de una lesión por mastocitoma felino donde se observa infiltrado difuso que compromete tejido graso y el tejido conectivo. Nótese la disgregación del tejido y la presencia de células inflamatorias. Aumento 20X.

FIGURA 3D
Examen histopatológico teñido con H&E, donde se observa el borde de la lesión tumoral y la dermis. Nótese la característica infiltrativa de la lesión. Aumento 10X.

FIGURA 4
A. Zona postquirurgica en región interescapular y cuello, nótese la gran dimensión de esta herida quirúrgica limpia con puntos de sutura simple con prolene 3-0. B. Felino en fase de recuperación con uso permanente del traje postquirurgico, se observa acceso venoso en la extremidad anterior derecha. Postquirúrgico de 3 días.

FIGURA 5
Evolución de herida postquirúrgica. A. Herida roja con tejido de granulación (flecha) en proceso de cicatrización (1 mes post intervención). Nótese la presencia de tejido epitelial en la periferia y una marcada regeneración de la piel en la zona posterior de la cicatriz. B. Herida en fase de epitelización con poco tejido de granulación, nótese el incremento de este tejido epitelial (flecha) con respecto a la imagen anterior, (1.5 meses post intervención). C. Postquirúrgico de 8 meses, se observa total repoblamiento capilar, (pelaje sano, herida totalmente cicatrizada en fase de maduración "remodelación").
